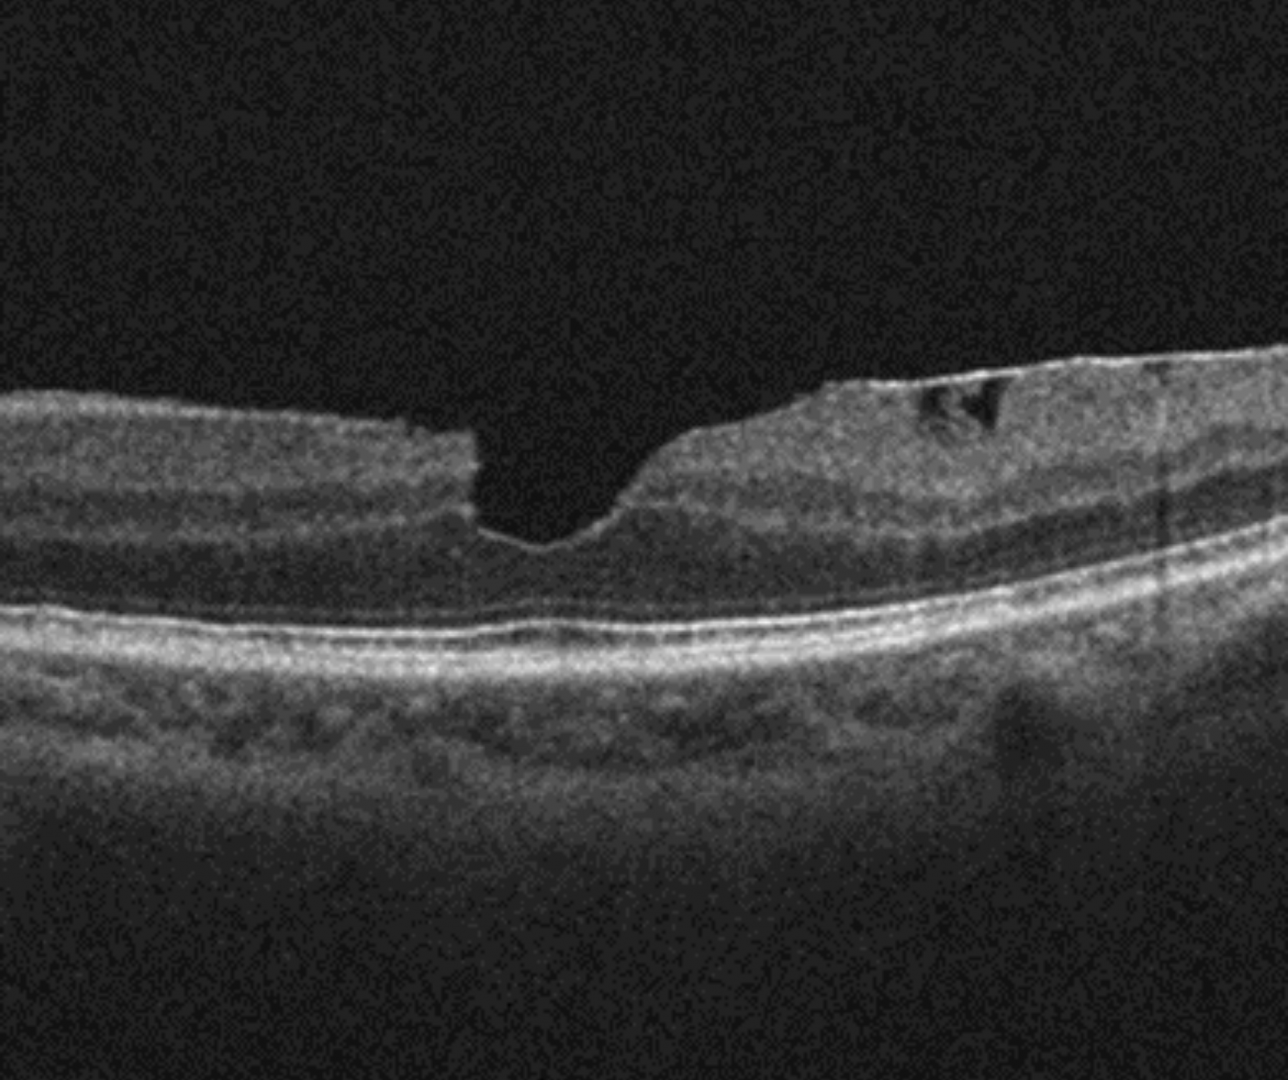

Overview
Macular pseudohole is caused by the invagination of the foveal via centripetal tangential traction of an epiretinal membrane (ERM).
Clinically, a discrete reddish round lesion can be seen at the macula and its appearance may mimic a full thickness macular hole.
On OCT, a macular pseudohole is defined by three characteristics: the presence of a verticalized or steepened foveal profile, retinal thickening and an ERM sparing the foveal centre.
Case Examples
References
Stalmans, P. Duker, J. Kaiser, PK. Heier, JS. Dugel, P et al. (2013) OCT-Based interpretation of the vitreomacular interface and indications for pharmacologic vitreolysis. Retina Volume 33 - Issue 10


